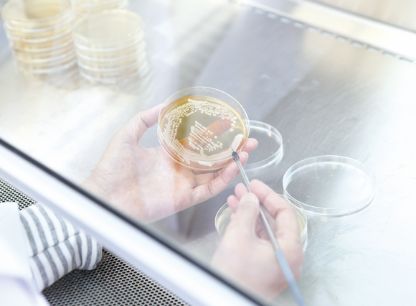

空が高くなり、鳥の声が変わって山々が秋色に染まり始めると、宝さがしに出かけたくなります。収穫を待つこがね色の稲穂や紅葉を眺め、熟れた柿をもいだり、栗やくるみを拾い集めたり。忘れていた歌をふと思い出すのもこんな時です。
そちらもお変わりありませんか。群言堂から、秋の「おりおり帖」をお届けします。深まる季節を前に、音楽をイメージした天然素材の衣や、からだをあたためる暮らしの雑貨など、長く愛せるものたちがいろいろ。「根のある暮らし」のあれこれが、あなたにも届きますように。
極細羊毛を編み上げた生地に洗いをかけて縮ませてから、揉んで表面に毛羽を立たせた「ウォッシャブルミルド」。薄手ながらあたたかく、上品な着姿を叶えます。ご自宅で洗濯できるのもポイント。
緯糸にシルク混糸を配した綿シルクワッフルは、やわらかな風合いと上品さを兼ね備えています。梯子刺繍のネックレスをつけ衿のようにあしらえば、シンプルなプルオーバーもレトロ可愛いおしゃれ着に。
緯糸にシルク混糸を配した綿シルクワッフルは、やわらかな風合いと上品さを兼ね備えています。梯子刺繍のネックレスをつけ衿のようにあしらえば、シンプルなプルオーバーもレトロ可愛いおしゃれ着に。

色と柄を愛でたいソックスあれこれ。
「元気でいてね」の思いを伝える
贈りものにもどうぞ。

朝、目覚めて袖を通したら、てきぱき働く心のスイッチオン!
家事にお出かけ、今日も私らしく。
忙しい朝。すぽっとかぶるだけで着られて、コーディネートに迷わなくてもすむワンピースは、女性たちの心強い味方。そこに母世代が愛用した「かっぽう着」の利点を取り入れたのが、群言堂の10年来のロングセラー、ワークワンピースです。
これを着れば、たちまち「よおし」と腕まくりな気持ちになるから不思議。おうち仕事はもちろん、「ちょっとそこまで」のお出かけも楽しくなって、前向きな気持ちを後押ししてくれます。

色違いで買い集め、日替わりで楽しむ方も多い定番。
今季は着こなしやすいベーシックカラーに加えて、
ぱっとはなやぐピンクも加わりました。

腕まくりした袖がピタッと止まる幅広リブは改良の末に完成した自信作。これでずり落ちる袖のストレスにさよなら。

脇下にもうけた三角マチで、肩や腕の可動性アップ。腕を思い切り上げる動作を妨げず、圧迫感を感じさせないから、窓拭きにも存分に集中できます。
これからのために、群言堂の
新しい取り組みが、始まっています。

少々くたびれていても、簡単には手放せないお気に入りの服。布の命がある限り、大切に最後まで使い切りたい。そんな声にお応えして2021年に発足したのが、群言堂の「お気に入り相談室」です。
小さな繕いはもちろん、服をほどいて別の形に仕立て替えたり、色褪せや汚れが気になる服を染め直したりといったカスタムオーダーが、ここでは可能。これまで群言堂がお受けしていた「お直し」は、服のデザインを変えない範囲の作業のみでしたが、「お気に入り相談室」の登場で、できることの幅はぐんと広がりました。
「メールやお手紙でお直しのご相談を何往復もしているうち、お洋服のこと以外の、お客様の日々の近況や、思い出話を聞かせていただくことも……」と話すのは、窓口担当の長見早苗。長年、商品の生地や縫製などの管理を受け持ってきたベテランです。長見にとって、お客様から届いた服を広げるのは、お客様の人生の痕跡に触れる瞬間でもあります。
お客様のご要望に合わせて、パタンナーと協力しながらお手当てした服は、世界でたった一枚の存在。新たな命を得て、これからお客様とどんな時を過ごすのか、想像するのもまた楽しいのです。

約30年前に群言堂本店で購入されたベスト。素材の風合いとあたたかさが気に入って、長年冬のホームウエアとして愛用されてきました。そろそろ着用の限界は感じつつも、捨てるには忍びないとご相談に持ち込まれました。


再利用できる生地が限られていたため、お孫さんに贈るベビー用ベストに仕立て直すことに。ご自宅で洗濯できるよう、生地も中綿も洗って縮ませてから、使えるパーツをはぎ合わせて完成。おばあちゃまのぬくもりを受け継ぐ愛情いっぱいの一枚です。



東京都のT様から、「傷みが気になりつつも捨てられなくて」と持ち込まれたコート。すでに廃業されたメーカーの生地が使われており、今では再現不可能なもの。



衿の形が気に入っているので生かしたいというT様のご要望を反映し、擦れや傷みのない生地を生かしてベストに。ポケット部に生地を横方向に切り替えて使っているのがポイントです。小さな残布を集めてつくったミニ手提げも添えました。

一本の糸が布になり、衣になる。
その一生にきちんと向きあうことが、
今、私たちに求められています。
人も、衣も、自然も、すこやかであるために、
今考えたい、これからの「始末」のかたち。
一本の糸が布になり、衣になる。
その一生にきちんと向きあうことが、
今、私たちに求められています。
人も、衣も、自然も、すこやかであるために、
今考えたい、これからの「始末」のかたち。
ものの命。その始まりから終わりまで、きちんと責任をもって生かし切ることを、昔の人々は「始末」と呼んで大切にしました。大地からの授かりものである綿や麻、羊毛を使って衣をつくる私たちは、世界や自然に対して一端の責任を負っています。いま改めて、私たちは現代に必要な「始末」のかたちを考えたい、そう思います。
たとえば土壌にも人にも負担の少ないオーガニックコットンや無染色ウールを使うこと。残布を無駄にせず使い切ること。あとで染め替えがしやすいよう綿糸縫製を取り入れること。糸が生まれ、衣となってとことん着尽くされるまでを見届けていく、そんな取り組みを少しずつ増やしていきたいと思っています。

あったかインナーにさっと使える万能生姜。
秋冬のからだにうれしい思いやり集めました。

年齢を重ねるほどに失われていく、ハリや透明感。そんなお肌の老化を加速させる原因のひとつとして、近年注目されているのが「糖化」です。さて、どういうことか、MeDu開発者のファン・ウェイに教えてもらいましょう。
「糖化」とは、体内に蓄積した過剰な糖質が、たんぱく質と結びついて AGEsという物質を作り出す現象のこと。これは揚げものやハンバーグに茶色い「コゲ」ができるのと同じ反応です。このAGEsが、体内だけでなく肌表面で発生すると、しわ、シミ、くすみの原因のひとつとなるのです。
「そこで、肌表面で発生する糖化現象をいかに抑えるか、が大切になります。MeDu 製品に配合されている梅花酵母エキスは、すぐれた保湿効果に加えて、この糖化現象の抑制効果※が認められている成分なんですよ」とファン。(※2015 年日本薬学会で発表)
梅花酵母エキスが優秀なのは、「保湿+抗糖化」というWの効果で、肌(角質層)に浸透してうるおいを保ちながら、エイジングケアも叶えてくれる点。MeDu のスキンケアアイテムは、どれもこの梅花酵母エキスを高濃度で配合。続けるほどにその人の肌本来の美しさが目覚めていくのです。
「糖化を抑制するためには、日々の暮らし方もとても大切です。たとえば食事のバランスに気を配ることや、お通じをよくすること、全身の筋肉量を減らさないことなどですね。つまり、巡りのよいからだを保つことが、若々しいお肌の秘訣なんですよ」。
エイジングケアに特効薬はなく、日々の積み重ねこそ大切ということ。だから今日もからだを動かし、楽しく食事をして、ごきげんに暮らしましょう。あなたの笑顔のそばに、MeDu はこれからも寄り添います。

石見銀山に咲く梅の花から発見された自然酵母。すぐれた保湿効果に加え、「抗糖化効果」が認められています。

房薇
(ファン・ウェイ)
農学博士。MeDu(めづ)開発者。
2009年の「梅花酵母」の発見以来、
その美容効果を研究中。

「これまでに出会ったカミツレと全然違う!」
と新田さんを感動させた南阿蘇のカミツレ。
二煎目も香りが生きています。
里山の植物を生かした「からだ想いの里茶」に
女性に寄り添う新しいフレーバーが仲間入りしました。
熟れたりんごを思わせる甘い香りの下から、荏胡麻や葛、生姜の風味がふくよかに立ちのぼって、ほっこり。「からだ想いの里茶」に新たに仲間入りした「カミツレと荏胡麻と葛」は、里山に伝わる薬草茶の知恵を生かした同シリーズの中でも、とくに女性の味方を意識したブレンドです。
ブレンド監修を担当したのは、日本各地に残る薬草文化を現代に生かす活動を行っている食卓研究家の新田理恵さん。女性のお守りとして、新田さんの頭に最初に思い浮かんだのが、出雲国風土記にも登場する薬草・葛でした。さいわい島根では、山に自生する葛から状態のよい葉と茎が手に入ります。そして葛の独特のクセを和らげるために選んだのが、はなやぎのあるカミツレ(カモミール)。
「熊本・南阿蘇で、無農薬で育てられたジャーマンカモミールは、香り立ちが力強く、試飲した時、思わず感動しました」と新田さん。そして、葛とカミツレの出会いに奥行きを与えるのが荏胡麻の葉と生姜。軽く焙煎した荏胡麻の葉が香ばしさを醸し出す一方で、おだやかな生姜の刺激が、ぽかぽかとした余韻を残します。
「このお茶はぜひ夜のリラックスタイムに飲んでいただきたいですね。茶葉ごとミルクと煮出したハーブミルクティもおすすめです。カミツレの香りは入眠に役立つと言われていますし、良質な睡眠は疲労の回復やホルモンバランスに欠かせないものですから」と新田さんは話します。
がんばった一日の終わり、パソコンやスマホのブルーライトから離れて、お気に入りのお茶でそっと緊張をほどくひとときを。ノンカフェインのやさしさが

がんばった一日の終わり、パソコンやスマホのブルーライトから離れて、お気に入りのお茶でそっと緊張をほどくひとときを。ノンカフェインのやさしさが全身を駆け巡って、ぐっすり、いい夢が見られそうです。
がんばった一日の終わり。ティーバッグにお湯を注ぐだけで、豊かな香りがこころとからだを解き放ちます。
「これまでに出会ったカミツレと全然違う!」と新田さんを感動させた南阿蘇のカミツレ。二煎目も香りが生きています。

がんばった一日の終わり。ティーバッグにお湯を注ぐだけで、
豊かな香りがこころとからだを解き放ちます。
今年38歳になる三女の奈緒子は、小学生の頃、七夕の短冊に「お母さんの後を継ぐ」と書いたことがあります。そんな彼女は今、5人の子を持つ母として、また町内の保育園を運営するNPOの理事として、このまちの子育てを支える役割を担っています。最近、私は思うのです。選んだ道こそ違えども、私も娘も、大きな川の流れの一部であり、この地で受け取ったものを次の誰かに手渡していく「恩送り」をしている点では同じなのだと。
東京の服飾専門学校で出会った旦那さまと結婚し、長男を生んだ奈緒子は、2012年、家族で大森町にUターン移住をしました。当初は、ふるさとでありながら、身の置き場が見つからないモヤモヤを抱え、悩んだ時期もあったようです。そんな彼女が殻を破るきっかけになったのが、保育士資格を取る勉強を始めたことでした。
資格取得を思い立った理由のひとつは、その頃、町内の幼稚園が存続の危機にあったこと。園児が2人にまで減ってしまい、保育士の確保さえ危ぶまれる中、「自分の町を自分の手で守らなくては」という思いが彼女を動かしたのです。その後は、耕した畑に種が落ちて芽吹くように、Iターン移住者が増え、2017年には1年に10人もの赤ちゃんが誕生するというベビーラッシュが到来。まさに「大森町の奇跡」でした。
娘とよく言うのは「ここでは“お互いさま”のスパンが長いよね」ということ。思い返せば彼女が幼い頃は、寝る間も惜しんで働いていた私に代わって、義母やご近所さんが彼女の面倒を見てくれました。そして今は、かつてお世話になったお宅のお孫さんを、奈緒子が見ているという塩梅。世代を超えて“お互いさま”が続いているのです。
人口400人という小さな町のいいところは、顔の見える誰かや町のために、自分にもできることがある、と思える点です。娘を横目で見つつ、私は私で、またもや普請道楽を発揮し、頼まれもしない古い家の修復に熱中する日々を送っています。先の使い道は考えず、その家が喜ぶように直してあげる。そうすれば自ずと家は生かされ、役割が与えられて、次の世代へとよい形で残っていくでしょう。私と娘、それぞれの「恩送り」は、これからも続いていきます。

